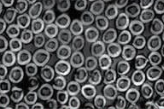

Custom Textile Solutions by Industry
Quantum partners with leading brands and manufacturers to deliver engineered textile solutions built around performance, durability, and scalability. Our vertically integrated manufacturing model allows us to design and produce custom woven fabrics, suspension textiles, and technical substrates tailored to the specific demands of each industry we serve.
From automotive seating systems and ergonomic office furniture to outdoor stadium seating, industrial filtration, and military applications, Quantum provides material solutions where traditional textiles fall short.

A Capability-Driven Approach to Industry Solutions
Quantum is not a catalog supplier. We are a capability-driven manufacturer, engineering materials at the yarn, fabric, and process level to solve real-world performance challenges. We deliver consistent, application-specific textile solutions that scale reliably from development through full production.
Industry Solutions We Support
Each industry presents unique performance, regulatory, and production challenges. Quantum’s integrated capabilities allow us to tailor solutions that meet these requirements without compromise.

Furniture & Office Seating
High-performance woven suspension fabrics engineered for comfort, breathability, ergonomic support, and long-term durability in office, task, and contract seating.

Automotive & Transportation
Lightweight B-surface suspension fabrics designed to replace heavier components in seat systems, improving durability and contributing to vehicle efficiency.

Outdoor & Stadium Seating
UV-resistant, weather-durable suspension fabrics engineered to deliver long-term comfort and structural integrity in outdoor and high-traffic public environments.

Industrial & Filtration
Custom-engineered woven substrates used as critical structural components in advanced industrial and filtration systems where precision and consistency are essential.
Military & Defense
Berry-compliant, domestically manufactured textiles designed for durability, lightweight strength, and performance in harsh military environments.
Vertically Integrated. Purpose Built. Made in the USA.
All Quantum solutions are supported by 100% U.S.-based manufacturing, providing customers with greater supply-chain security, tighter quality control, and faster collaboration throughout the product lifecycle.
Our integrated approach enables:
Quantum engineers materials at the polymer, yarn, and fabric level, allowing us to develop application-specific solutions rather than forcing customers into off-the-shelf products. Our team collaborates closely with customers to define performance requirements, then designs yarn systems, fabric constructions, and processing methods to meet those needs.
This approach supports highly specialized applications across seating, industrial, filtration, military, and transportation markets.
Unlike commodity textile manufacturers that require large minimums, Quantum offers significantly lower MOQs, making it easier to prototype, validate, and launch new programs without excessive waste or upfront cost. Lower MOQs also provide agility for customers managing: Pilot programs and limited production runs, Multiple product variants, Color and design flexibility.
Because extrusion, weaving, fabrication, and development are all handled in-house, Quantum can iterate quickly during the development process. This reduces back-and-forth with multiple suppliers and allows faster refinement of materials based on real-world testing and feedback.All fabric customization is supported by in-house design, engineering, and development teams who collaborate closely with customers from concept through production. This integrated approach allows Quantum to rapidly prototype, refine, and scale woven solutions that align with performance requirements, manufacturing constraints, and long-term program goals.
Quantum supports long-term production programs through controlled, domestic manufacturing and vertically integrated quality systems. By owning critical process steps, we reduce supply chain variability and ensure consistent performance over multi-year lifecycles.
This stability is especially valuable for programs where performance consistency, compliance, and supply reliability are critical.

Engineered from the Process Up
Quantum’s industry solutions begin with manufacturing control. Our ability to develop materials internally allows us to align performance, consistency, and production scale with the real demands of each application.


Let’s Engineer the Right Textile Solution
Whether you’re refining an existing product or developing something entirely new, Quantum’s team works alongside you to engineer textile solutions that meet performance goals and production realities.
